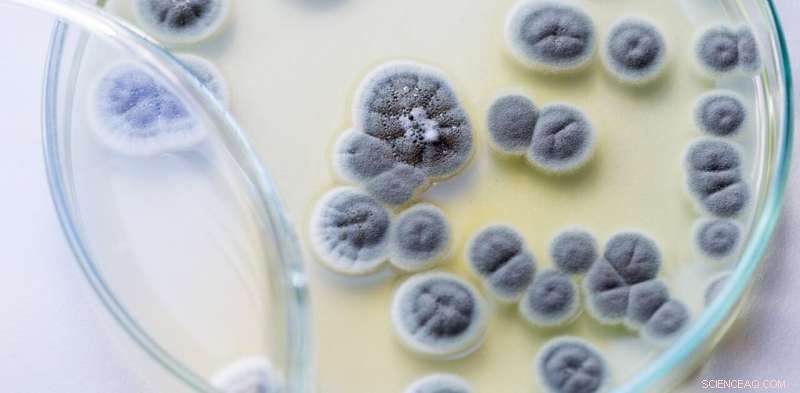
Debunking the Myth: How Misinterpretations of Penicillin’s History Shape Science Progress

Credit: Rattiya Thongdumhyu/Shutterstock
Many professions have creation myths about much-revered pioneers. For nursing, it is Florence Nightingale in Scutari, flitting between beds bearing her lamp. For engineers, it is Isambard Kingdom Brunel, driving railway lines across the countryside and building ships. These myths often tell us more about how professions want to be seen than about the historic events on which they are based.
One of the myths in medical science is the discovery of penicillin. It has been retold to generations of school children: Alexander Fleming came back from his holidays in 1928 to his laboratory at St Mary's Hospital in London and looked at some petri dishes before throwing them away. On one of the dishes he sees a mould growing, with a clearing around it where the bacteria had been killed. A eureka moment allows him to deduce that the fungus is releasing a molecule that kills the bacteria.
The action then moves to Oxford where Howard Florey and Ernst Chain discover how to isolate the molecule, now called penicillin. They realise the importance of the drug for the war effort, and with the help of American companies, large amounts of penicillin arrive just in time to treat wounded allied soldiers during World War II. The curtain call is taken by Fleming, Chain and Florey when they win a Nobel Prize in 1945.
This is a very satisfying story. It includes the serendipity of a contaminated culture dish (the Fountains Abbey pub in nearby Praed Street makes unlikely claims that the mould came from their beer, tying the discovery of penicillin into British culture). It involves a moment of effortless brilliance, with Fleming seeing the implications of the clearing. It describes research working out in a predictable and rapid manner; once Fleming saw the dish, it was just a matter of time before the wonder drug started saving lives.
Not a priority
Much of this is wrong. The story of Fleming seeing the clearing first appeared in 1944. It is not supported by the notes he wrote at the time and is difficult to reconcile with the growth of Penicillium and Staphylococcus aureus, nor by how penicillin works. It appeared at a time of great tension and competition between St Mary's and Oxford scientists.
What is often missed is the time and effort it took to get from Fleming's initial discovery to production of the drug. In part this is because it was not a priority for Fleming. It was not obvious that penicillin was of any interest, when results were presented at scientific meetings, they were often met with indifference.
It was very hard to isolate the active ingredient of the "mould juice"—several scientists tried and failed. It needed the biochemical skills and inventiveness of the Oxford scientists to solve this problem.
The Oxford group made superhuman efforts to make enough penicillin to treat patients, initially growing the mould in bedpans.
The first person treated was a policeman, Albert Alexander, who had an uncontrolled bacterial infection following a rose scratch. He responded dramatically to penicillin, seeming to recover. But ten days later, he relapsed, and despite having recycled penicillin from his urine, supplies ran out and he died of his infection.
The final step was the scaling up and industrialisation. This stage is often forgotten. UK companies did not have the capacity, resources or vision to manufacture penicillin. Florey turned to US industries who developed new ways to isolate penicillin. This was not trivial, and by 1945 US companies were making 6.8 trillion units – slightly more than 4,000kg of the drug a year.
Long and winding road
It took 16 years from initial observation to useful production of penicillin, and it would have been much longer without the impetus given by the war. Exploitation of scientific results takes time, persistence and different skills.
But is the final part of the story true? Did penicillin help win the war? It certainly saved thousands of soldiers from dying of gangrene and sepsis. But its greatest contribution to the war effort may have been the treatment of gonorrhoea, helping keep the army at full strength.
During the invasion of Sicily, when penicillin was still in short supply, some argued that it should be reserved for wounded soldiers, rather than to relieve "scallywags" of the consequences of their own indiscretions. This was overruled by Churchill, who said it was to be used to obtain the "best military advantage."
What are the dangers of the penicillin myth? I suggest that it emphasises a model of scientific discovery that is effortless and dependent on individual genius. That is not fair on Fleming, he was prepared for his discovery by years of hard work, and it involved a series of difficult experiments.
It also suggests that, once the discovery is made, science proceeds down a predictable path to exploitation. This is not the case, the reason it took time to develop penicillin is because it was a hard thing to do and its potential was not obvious.
Finally, the myth concentrates on individuals, in particular Fleming. While his contribution was vital, that of Florey and Chain was equally important. The contribution of Norman Heatley was key to the biochemical isolation. Countless other scientists and industrialists were involved. Edward Mellanby, the secretary of the Medical Research Council, saw the potential and sorted much of the funding. Patients, doctors, nurses and technicians, including the "penicillin girls" who prepared the penicillin, all played their role. Science is a shared enterprise.
Myths are important, but sometimes it is useful to look behind them to understand how science really works.
This article is republished from The Conversation under a Creative Commons license. Read the original article.